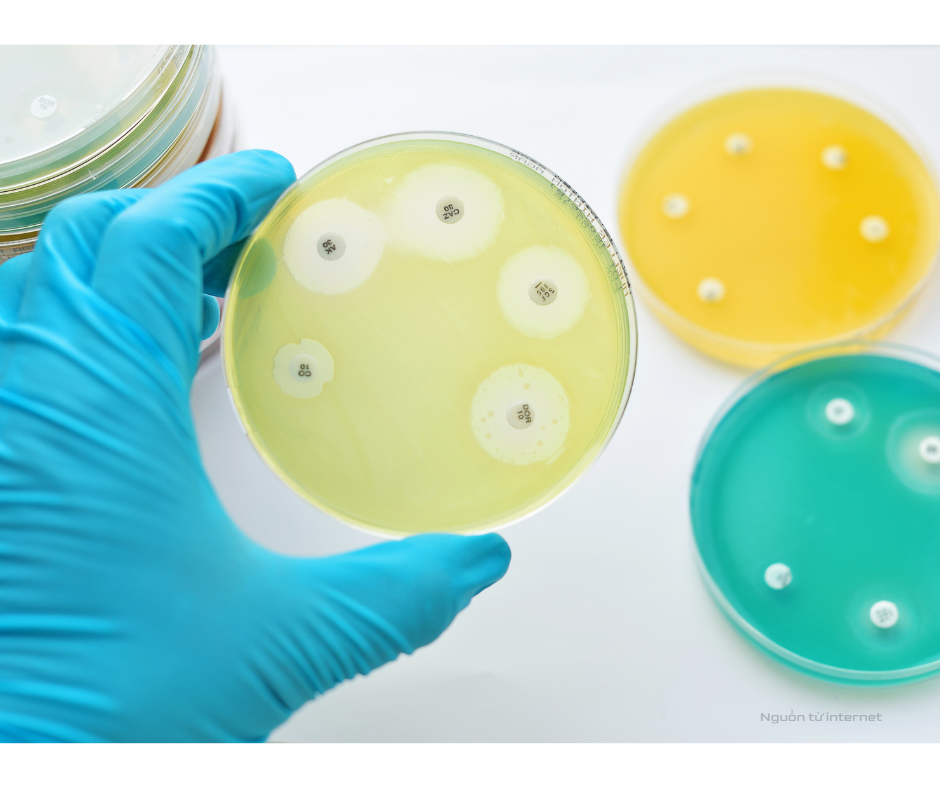
Kháng sinh đồ

Trong điều trị nhiễm khuẩn, việc sử dụng kháng sinh cần được cân nhắc cẩn trọng. Mỗi loại vi khuẩn có mức độ nhạy cảm khác nhau với từng loại thuốc, vì vậy một kháng sinh hiệu quả với người này chưa chắc đã phù hợp với người khác. Thực tế, việc sử dụng kháng sinh theo kinh nghiệm hoặc theo đơn thuốc cũ vẫn còn khá phổ biến, dẫn đến điều trị kém hiệu quả và làm gia tăng nguy cơ kháng thuốc.
Trong bối cảnh đó, Kháng sinh đồ đóng vai trò quan trọng trong việc xác định loại kháng sinh phù hợp với vi khuẩn gây bệnh, giúp quá trình điều trị đạt hiệu quả cao hơn.
Kháng sinh đồ là gì?
Kháng sinh đồ là xét nghiệm giúp xác định vi khuẩn gây bệnh nhạy hay kháng với loại kháng sinh nào.
Quy trình thực hiện cơ bản:
- Lấy mẫu: Bác sĩ chỉ định lấy mẫu bệnh phẩm từ cơ thể Người bệnh (máu, nước tiểu, đờm,…).
- Nuôi cấy: Các loại mẫu này được nuôi cấy để xác định vi khuẩn gây bệnh.
- Thử thuốc: Vi khuẩn được cho tiếp xúc với các loại kháng sinh khác nhau.
Kết quả trả về được phân loại:
- Nhạy (Sensitive – S): Kháng sinh có hiệu quả tốt.
- Trung gian (Intermediate – I): Thuốc có tác dụng nhưng có hạn chế, cần cân nhắc tăng liều hoặc phối hợp thêm.
- Kháng (Resistant – R): Kháng sinh không còn tác dụng.
Bác sĩ lựa chọn loại thuốc phù hợp cho Người bệnh dựa trên các tiêu chí trên.
Lợi ích của việc làm Kháng sinh đồ
- Chọn đúng thuốc, trị đúng bệnh
Mỗi loại vi khuẩn có đặc tính nhạy hoặc kháng khác nhau đối với từng loại kháng sinh. Nếu điều trị theo kinh nghiệm mà không có dữ liệu cụ thể dẫn đến nguy cơ chọn sai thuốc.
Kháng sinh đồ cung cấp thông tin rõ ràng để Bác sĩ kê đơn chính xác hơn, từ đó rút ngắn thời gian điều trị.
- Giảm nguy cơ kháng kháng sinh
Kháng thuốc xảy ra khi vi khuẩn thay đổi đặc tính, khiến kháng sinh trước đây hiệu quả nay không còn khả năng kiểm soát chúng. Một trong những nguyên chính là sử dụng kháng sinh không phù hợp hoặc không đủ liều.
Khi dùng thuốc theo đúng chỉ định và liều lượng, vi khuẩn được kiểm soát hiệu quả hơn, giảm khả năng “thích nghi” và phát triển tính kháng.
- Tiết kiệm chi phí và giảm biến chứng
Điều trị lâu dài do dùng chưa đúng loại thuốc có thể khiến tình trạng nhiễm khuẩn nặng, tăng nguy cơ biến chứng hoặc nhập viện.
Việc lựa chọn đúng kháng sinh từ đầu giúp quá trình hồi phục diễn ra thuận lợi, đồng thời giảm chi phí do phải điều trị bổ sung.
Khi nào cần làm Kháng sinh đồ?
Phương pháp này thường được chỉ định trong các tình huống cụ thể để đảm bảo an toàn:
- Người bệnh bị nhiễm khuẩn nặng hoặc có dấu hiệu nhiễm trùng máu.
- Các tình trạng viêm nhiễm tái phát nhiều lần.
- Điều trị kháng sinh nhưng không có cải thiện.

Vai trò của Kháng sinh đồ trong kiểm soát kháng thuốc
Kháng kháng sinh đang là thách thức lớn đối với Y tế toàn cầu. Vi khuẩn kháng thuốc làm giảm hiệu quả điều trị và tăng nguy cơ tử vong ở nhiều bệnh lý nhiễm trùng.
Thông qua việc tổng hợp và theo dõi kết quả Kháng sinh đồ theo thời gian, Cơ sở Y tế có thể:
- Đánh giá mức độ kháng thuốc tại địa phương.
- Điều chỉnh phác đồ điều trị phù hợp với tình hình thực tế.
- Quản lý việc sử dụng kháng sinh hợp lý hơn.
Những lưu ý quan trọng cho Người bệnh
Để quá trình điều trị đạt hiệu quả, mỗi cá nhân cần thực hiện tốt các nguyên tắc:
- Không tự mua thuốc (Kháng sinh): Chỉ dùng kháng sinh khi có chỉ định của Bác sĩ.
- Tuân thủ liều lượng: Tuyệt đối không dừng thuốc ngay khi vừa thấy triệu chứng thuyên giảm, cần uống đủ liều lượng theo chỉ định.
- Trao đổi trực tiếp: Người bệnh chủ động báo lại với Bác sĩ về tình trạng bệnh nếu có dấu hiệu diễn tiến phức tạp.
Kết luận
Kháng sinh không phải là giải pháp cho mọi tình trạng viêm nhiễm. Việc lựa chọn thuốc cần dựa trên dữ liệu cụ thể thay vì phỏng đoán.
Kháng sinh đồ giúp xác định chính xác loại thuốc phù hợp với vi khuẩn gây bệnh, từ đó nâng cao hiệu quả điều trị và hạn chế nguy cơ kháng thuốc cho Người bệnh.
*Bài viết cung cấp góc nhìn tổng quan về kháng sinh đồ trong thực hành xét nghiệm và điều trị nhiễm khuẩn*
